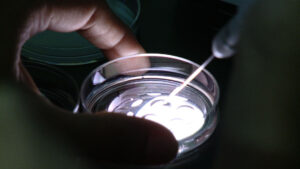

Movie Name – Anything You Lose
Director Name – Irina Vodar

Hello Irina! Welcome to SIFF
Hello and thank you so much for including me in your Interview section! I love your well-thought-out questions.
1. What made you take up such a sensitive subject and make a documentary about it? A well-thought-out project.
The idea of making a documentary about Reproductive Technologies and the reproductive journey came about in mid-stream, when my husband and I were already deep in the process.
I was surprised to learn that the road ahead was long and arduous, the outcome may be uncertain, and my emotional involvement was at an all-time high. What’s more, all publications on the subject featured support for pregnant women well into their forties. I felt ostracized, unacknowledged, and looked for ways to cope with my experience. I used the camera to shield myself from the impact. I wanted to keep a record of the journey, to make sense out of conflicting feelings, and to remember that I really tried.

2. The pain and agony of not being able to conceive has definitely touched a chord in our hearts. What are your insights on these from a third-person perspective?
It is one thing to try and not being able to conceive, it is a private pain that takes time to process. But in addition, we find ourselves in a society desensitized by broad spread of reproductive services promotions. Since Reproductive Treatments are presented as a panacea for late bloomers wanting to create a family, instead of comfort we receive a list of cutting-edge procedures that should guarantee results. Somehow, the notion of attachment to the embryos, emotional depletion and financial ruin are taken out of the equation. If you give up, you didn’t want it badly enough.
3. Anything you lose – the name of the feature documentary film! What made you take up this particular documentary movie name? Is it because the couple is ready to lose everything to have a child they can call their own?
Anything You Lose is a partial quote from Rumi, a great Persian poet. “Don’t grieve. Anything You Lose comes around in another form”—he says. I felt the title was appropriate for the poetic connotation concealed within, a hope for a renewal. Yet also, the title conveys a dire straits devotion to the end result, as you have rightly guessed, an invested couple is ready to lose everything to have a child they can call their own.

4. A 7-year journey full of failures and not being able to conceive. It’s emotionally devastating – what’s your take on this topic? How far would every couple be ready to go for having a child of their own bloodline?
Before my husband and I embarked on the journey to conceive, we knew what everyone else does—that infertility is defined as being unable to conceive after a year of unprotected sex, and that there are Reproductive Technologies available to aid those who might need assistance. We came into the process with trusting hearts and minds, and sought medical advice and services that would not be too taxing on the wallet. As time went by, we started feeling misalignment between our own experience and what was advertised. In media and press I read about many miracles, and science making progress, yet we couldn’t get the coveted result. It felt like there was something wrong with me, that I was singled out. I didn’t notice how I started suffering from tunnel vision, where only one thing mattered— to have a miracle baby just like other people, closing the gap between reality and miracles.
I speak of isolation and addiction to the treatments because when we roll the dice with another cycle, we are so close to joining in the ranks of those who defied aging and got the winning ticket. And every time it doesn’t work, the weight of all the choices that led us to this point come crushing down, demanding facing the reality and consequences of those actions. It’s very hard to quit and say I’m done. The hardships also come at a price to family and loved ones, and all of it is taking place in isolation, unacknowledged.
5. Why isn’t adoption a choice when the couple has experienced so many failures and challenges along the way?
Adoption is frequently advised as a way of mitigating childlessness. Adoption is a beautiful option, rhymes a poster. It is a blessing to take an orphan and raise them as your own. But after being emotionally depleted and repeatedly heartbroken, it’s not so easy to shake it off and be a source of joy. Adopted children undergo an early childhood trauma, and need more love and care than biologically your own. You wouldn’t suggest adoption to a grieving mother who just lost her child to fill that void, but we routinely say it to the grieving patients. Besides, the need for biological link is also strongly prevalent in adopted children, who will go on the quest of finding real parents once they come of age, unearthing insecurities that were not processed. The process of getting cleared for adoption is rigorous—there are many parents who would not get approved to adopt their own children.
6. Don’t you think that IVF and other methods of conceiving have adverse effects on health too? We are talking about the physical repercussions and side effects here!
IVF comes with a plethora of side effects: there’s breast tenderness due to high estrogen levels, menopausal symptoms due to the contents of injectables (pregnant mare urine), heart palpitations, lightheadedness, mood swings, severe weight gain. Some of the side effects may have cumulative effect over the years of treatments and currently are unacknowledged. Googling the symptoms will return the least problematic list, it varies based on the hormonal dosage and time of exposure.
Recent research highlights that natural pregnancy after fertility treatment is not an unusual event, challenging prevailing beliefs held by women, healthcare professionals, and the media. [Source]
7. The physical distress caused by reproductive treatments can adversely affect mental stress and strain as well. What’s your take on this?
Reproductive Technologies delve into the most sensitive area of the human psyche, the future generation. It’s normal for a girl to play with dolls, and for a young woman to love all children in preparation of someday becoming a mother. It’s normal for a woman undergoing IVF to love the idea of her unborn child. But to endure expectations that frequently (at least 70% of the time) do not produce results, we block our emotional attachment. With time, suppression of emotional responses catches up and manifests in mental stress. Half experience clinically significant depression and anxiety, reaching levels that can lead to post-traumatic stress disorder (PTSD). These symptoms can be found in men as well, as ability to produce an heir can be of great importance to a man’s sense of self-worth.
8. As a woman how would you describe this particular stress and trauma of not being able to conceive a child?
In my youth, I never gave much thought to having children and a family. I was driven by curiosity about the world, career and accomplishments, and was very happy. In that regard, I am a typical modern woman. When I got married and set off on the quest to have a child at 38 years of age, a certain tender valve opened in my heart, some call it a maternal instinct. I started getting ready to experience my life from a different vantage point, as a mother ushering a new life. I dreamed of passing on traditions of my family, and everything I have learned and accumulated. It was a gradual experience of adjusting to reality. My husband was of sound financial background, and we were certain that nothing could stand in our way—we wanted to be parents, were both responsible and driven. The pain of not being able to have children is existential. It’s not a broken bone that heals after a few months in a cast, affecting no one but yourself.
It’s something intangible that affects your family and circle of friends, how you perceive yourself and how your life is going to develop further. Instead of looking forward to the family milestones laid out by traditions, I lived for 14 years through the dark night of the soul, in a vacuum, devoid of meaning and any social interaction. My former self dissolved away. I do not like to sound melodramatic, but the seriousness of this challenge cannot be underestimated. Frequently, people who have gone this route do not like to think back to the dark days, and meantime, it deserves a massive warning. I kept repeating to myself that I just need to finish the edit, and then I can die. Life lost its luster and direction, and I lasted through sheer willpower to complete the film project. I had to build a new identity from scratch of what was available around me, and learn again to wish and dream. It’s been transformative. This film is a tribute to the dignity of effort, regardless of the outcome.

9. The documentary has been wonderful. How about making a movie on this subject?
As one viewer said, “It is a documentary, and it brings you back to reality”. There’s much to be done in terms of distribution. My dream is to have the film distributed educationally in colleges and schools around the world, in workplaces, hospitals, clinics, and in therapist’s offices. I think the power of the film comes from its documentary aspect. We know we’re witnessing real-life events, they’re factual and are not scripted.
10. We loved having you here! Hope you enjoyed working with SIFF!
It’s been my pleasure to be included in the roster of great films at SIFF. I am particularly grateful for your thought-provoking questions for this interview. I feel we’ve touched upon some deep-rooted concepts, and I sincerely hope the interview and the film will ring some bells. My thanks and compliments to SIFF!
DIRECTOR PRODUCER EDITOR
Irina Vodar is an award-winning filmmaker and graphic designer with over twenty years of experience in film and Broadcast Design with ABC News. As an Indie Filmmaker, Irina wrote, produced and directed two full-length documentary films. Her debut doc feature Miss Gulag, produced in association with Neihausen-Yatskova Films on a beauty pageant in a Russian prison for women, premiered at the Berlin Film Festival in 2007 (available on Amazon Prime).
Her second documentary Anything You Lose, an insightful portrayal of infertility journey, won funding from the New York State Council on the Arts (NYSCA) and went viral on the Indie Film Festival circuit with a 3X WIN at IndieFest Film Awards in 2023.